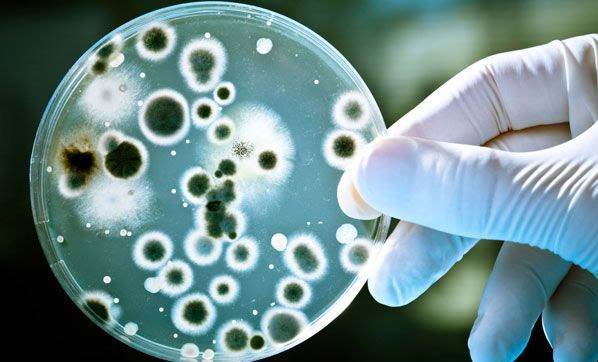
Bakteriden ölümler meme kanserini solladı

‘Süper bakteriler’ nedeniyle yılda 12 bin kişinin hayatını kaybettiğini açıklayan İngiltere Sepsis Merkezi, göğüs kanseri nedeniyle ölenlerin sayısını 11 bin 500 olarak duyurdu. Süper bakteriler, bilinçsiz ilaç kullanımı nedeniyle antibiyotiklere karşı direnç kazanıyor. Bilim insanları, 2050 yılında en az en az 10 milyon insanın süper bakteriler nedeniyle öleceğini tahmin ediyor.
Bakteriden ölümler meme kanserini solladı
İngiliz bilim insanları, süper bakteriler nedeniyle hayatını kaybedenlerin sayısının, göğüs kanseri nedeniyle ölenleri geride bıraktığını açıkladı.
Yayınlanma :
12.12.2016 16:55
Yorum Yazma Kuralları
Lütfen yorum yaparken veya bir yorumu yanıtlarken aşağıda yer alan yorum yazma kurallarına dikkat ediniz.
Türkiye Cumhuriyeti yasalarına aykırı, suç veya suçluyu övme amaçlı yorumlar yapmayınız.
Küfür, argo, hakaret içerikli, nefret uyandıracak veya nefreti körükleyecek yorumlar yapmayınız.
Irkçı, cinsiyetçi, kişilik haklarını zedeleyen, taciz amaçlı veya saldırgan ifadeler kullanmayınız.
Türkçe imla kurallarına ve noktalama işaretlerine uygun cümleler kurmaya özen gösteriniz.
Yorumunuzu tamamı büyük harflerden oluşacak şekilde yazmayınız.
Gizli veya açık biçimde reklam, tanıtım amaçlı yorumlar yapmayınız.
Kendinizin veya bir başkasının kişisel bilgilerini paylaşmayınız.
Yorumlarınızın hukuki sorumluluğunu üstlendiğinizi, talep edilmesi halinde bilgilerinizin yetkili makamlarla paylaşılacağını unutmayınız.

Yorumlar
Kalan Karakter: